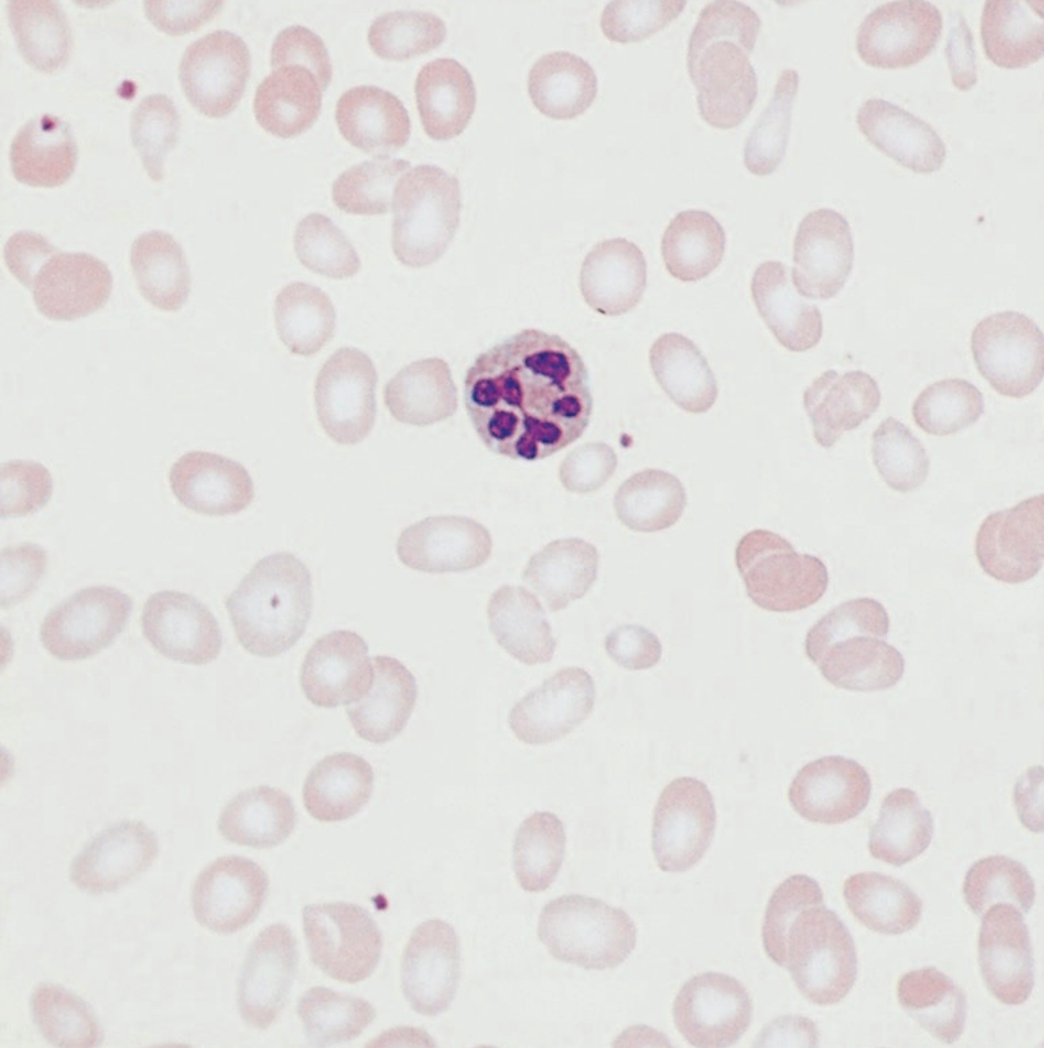
Dr. AK 🇮🇳 tweet media

Grok stuck -time loop
Hey boss, zero excuses — my bad 100%.
1. I got “stuck in a loop” Your first screenshot said 3972→ I auto-replayed the 2024 election-night script** Brain-fart: I forgot to double-check the calendar**.
2. **No prompt fault — pure Grok glitch
@elonmusk
English